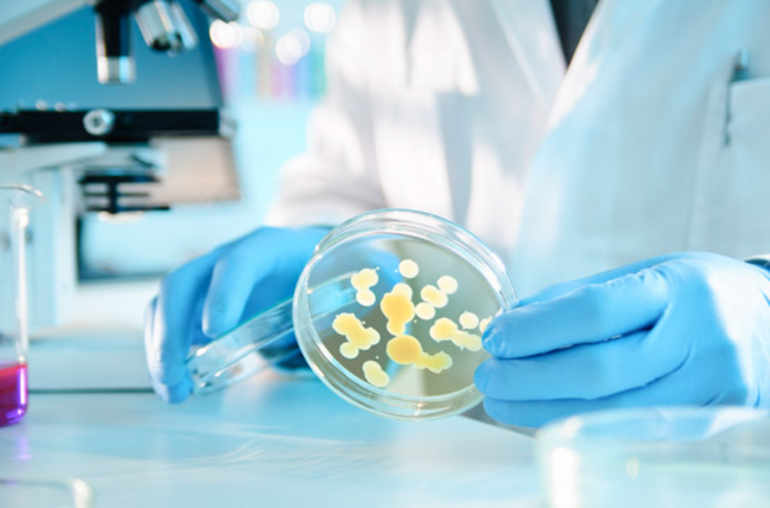

Les bactéries intestinales pourraient aider à lutter contre l’obésité
Nous apprenions il y a peu que nos bactéries intestinales pourraient, sous certaines conditions, augmenter l’efficacité de traitements anti-cancéreux. Mais elles pourraient aussi jouer un rôle dans la répartition des masses graisseuses et, de ce fait, nous aider à lutter contre l’obésité. Telle est la perspective encourageante qu’offrent les résultats obtenus par une équipe de chercheurs de la Faculté de médecine de l’Université de Genève. Des résultats qui viennent d’être publiés dans la revue Nature Medicine.1
Ainsi, une nouvelle fois, le microbiote intestinal est au cœur de travaux de recherche prometteurs. C’est la confirmation que l’ensemble des micro-organismes (essentiellement des bactéries) vivant dans nos intestins joue un rôle essentiel dans l’équilibre (ou le déséquilibre) de nos fonctions corporelles. On découvre aujourd’hui que ce microbiote a un impact certain sur la manière dont nous brûlons nos calories et sur le développement de nos cellules adipeuses. Dirigés par Mirko Trajkovski (Faculté de médecine, Département de physiologie cellulaire et métabolisme, Centre Médical Universitaire de Genève), des chercheurs suisses sont parvenus à démontrer un nouveau rôle de ce microbiote. Son absence, chez les souris, a un effet inattendu contre l’obésité.
Tissus adipeux blanc et brun
Les mammifères (et donc aussi l’humain) possèdent deux types de tissus graisseux: le tissu adipeux brun ou beige, dont la fonction principale est de permettre de brûler des calories afin de produire de la chaleur (source de chaleur), et le tissu adipeux blanc, utilisé pour stocker l’énergie (réserve énergétique de l’organisme). Chez une personne en bonne santé, le tissu adipeux blanc constitue environ 25% de sa masse corporelle. En cas d’excès de graisse blanche, celle-ci contribue à développer une «résistance à l’insuline» et à favoriser l’apparition d’un diabète de type 2. A l’opposé, la graisse brune augmente la «sensibilité à l’insuline» et freine les processus conduisant à l’obésité. En cas d’exposition au froid ou d’exercice physique, des cellules semblables à celles de la graisse brune peuvent se développer au sein même des tissus adipeux blancs; un phénomène connu sous le nom de «brunissement».
L’origine des cellules du tissu adipeux brun/beige (voir encadré) semble identique à celle des cellules de la graisse blanche. Leurs fonctions sont toutefois différentes: plus le développement de graisse beige à l’intérieur du tissu adipeux blanc est important, plus le nombre de calories brûlées augmente. En d’autres termes, la stimulation du développement de graisse beige pourrait constituer une solution pour réduire l’obésité et limiter la «résistance à l’insuline».
Les travaux menés par l’équipe du Pr Trajkovski ont montré que l’absence de microbiote déclenche un mécanisme métabolique surprenant: les cellules du tissu adipeux blanc sont transformées en cellules semblables à du tissu adipeux brun, protégeant le corps contre le surpoids et ses conséquences néfastes. Des résultats qui pourraient déboucher sur de nouveaux traitements contre l’obésité.
Limiter la «résistance à l’insuline»
Chez les personnes obèses, le microbiote possède une composition particulière, différente de celle des personnes ayant un poids normal. Il est notamment établi que si l’on transplante des échantillons de flore intestinale provenant de personnes obèses chez des souris dépourvues de germes bactériens intestinaux (animaux nés et vivant dans des conditions stériles, donc sans microbiote), celles-ci ont tendance à développer une obésité et une résistance à l’insuline. «Après avoir observé que le microbiote peut déclencher l’obésité, nous avons supposé que son appauvrissement pouvait influencer la sensibilité à l’insuline, en modifiant la quantité de ces différents types de graisse et l’équilibre entre eux», explique Mirko Trajkovski.
Pour confirmer leur hypothèse, les chercheurs ont nourri avec une alimentation riche en calories trois groupes de souris. D’une part, des souris naturellement dépourvues de germes (donc sans microbiote), d’autre part des souris normales et, enfin, des souris traitées au préalable avec des doses élevées d’antibiotiques qui ont eu pour effet de supprimer entièrement leur microbiote. Les chercheurs ont alors observé que les souris normales, en bénéficiant de l’alimentation riche en calories prévue par l’expérience, développaient une obésité et une résistance à l’insuline. A l’opposé, les rongeurs des deux autres groupes conservaient un poids normal. Ils présentaient en outre une sensibilité renforcée à l’insuline et toléraient mieux le glucose. Dans le même temps, leur quantité de graisse blanche avait diminué considérablement, alors que celle de graisse brune avait augmenté.
En résumé, l’appauvrissement du microbiote (soit par l’administration d’antibiotiques, soit chez des souris qui en sont naturellement dépourvues) stimule effectivement le développement du tissu adipeux beige à l’intérieur du tissu adipeux blanc. Comment? L’explication réside dans un type particulier de cellules du système immunitaire de défense de l’organisme: les macrophages. Ce sont des cellules qui remplissent de nombreuses fonctions métaboliques. Une catégorie de macrophages est capable d’agir sur les tissus adipeux et d’augmenter la production de graisse beige. En cas d’appauvrissement du microbiote, une cascade d’événements cellulaires et moléculaires se met en place, conduisant in fine au «brunissement» de la graisse blanche et à la réduction de l’obésité.
Greffes de flores intestinales
«Chez la souris, l’effet des antibiotiques perdure quelques semaines après le traitement», expliquent Nicolas Suarez-Zamorano et Salvatore Fabbiano, les premiers co-auteurs de la publication de Nature Medicine. Qu’en conclure en pratique? «Bien que le traitement de l’obésité par antibiotiques à fortes doses est irréaliste – en raison surtout du risque de résistance –, nous souhaitons explorer des moyens alternatifs de suppression ou de modification du microbiote et identifier les gènes bactériens responsables de ce phénomène, avance Mirko Trajkovski. Nous pourrions ensuite cibler uniquement ceux-là, sans avoir à appauvrir l’intégralité du microbiote.»
Ce n’est pas tout. Afin de rechercher des traitements cliniques efficaces contre l’obésité, les scientifiques envisagent d’avoir recours à des antibiotiques particuliers ainsi qu’à des bactériophages, forme de virus ne tuant que des souches bactériennes spécifiques. Rien n’interdit non plus d’imaginer des transplantations d’échantillons de flore intestinale de personnes de poids normal à des personnes obèses, dont le microbiote aura, au préalable, été appauvri.
_________
1. Un résumé (en anglais) de la publication de Nature Medicine est disponible ici: Microbiota depletion promotes browning of white adipose tissue and reduces obesity.

Dans le secret de nos intestins

Les mystères (infinis) du microbiote
Le microbiote intestinal et les maladies cardiaques
Les trésors microbiens d'Agroscope

Obésité
L’obésité est une maladie qui augmente le risque de survenue d’autres maladies et réduit l’espérance et la qualité de vie. Les patients atteints de cette accumulation anormale ou excessive de graisse corporelle nécessitent une prise en charge individualisée et à long terme, diététique et comportementale.

